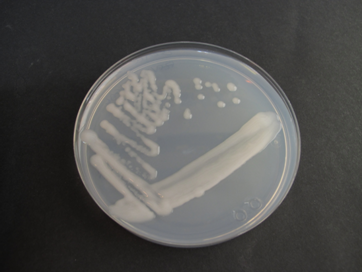

Rhizobium Agar USAL – Medio para aislamiento y detección de Rhizobium (patente Universidad de Salamanca – exclusiva MICROKIT)
El Rhizobium Agar USAL es un medio de cultivo selectivo desarrollado a partir de la patente de la Universidad de Salamanca (USAL), explotada en exclusiva por MICROKIT.
Diseñado específicamente para el aislamiento y cultivo de bacterias del género Rhizobium, rizobacterias y endófitos, este medio ha sido optimizado para ofrecer resultados fiables y reproducibles en laboratorios de microbiología, investigación y control de calidad agrícola.
Ficha técnica oficial en PDF (Rhizobium Agar USAL)
Rhizobium leguminosarum foto USAL
Características y composición del Rhizobium Agar USAL
El medio se formula con componentes cuidadosamente seleccionados para favorecer el crecimiento de bacterias fijadoras de nitrógeno, especialmente aquellas que utilizan manitol como fuente de carbono.
Composición por litro:
- Manitol – 7 g
- Fosfato monopotásico – 0,15 g
- Fosfato dipotásico – 0,4 g
- Nitrato amónico – 1 g
- Extracto de levadura – 0,5 g
- Agar-Agar – 17 g
- pH final: 7,0 ± 0,2
El medio presenta un color marfil tanto en su forma deshidratada como tras la preparación.
Preparación del medio
- Disolver 26,05 g del medio deshidratado en 1 litro de agua bidestilada.
- Calentar hasta ebullición, agitando para lograr una completa homogeneización.
- Dispensar en tubos o frascos adecuados.
- Esterilizar en autoclave a 121 °C durante 20 minutos.
- Evitar el sobrecalentamiento para mantener las propiedades del medio.
⚠️ Uso exclusivo en laboratorio.
Conservar el bote bien cerrado, en lugar seco, fresco y oscuro.
Agitar antes de usar para asegurar la homogeneización de los componentes.
Presentaciones disponibles
- Bote de 500 g
- Bidón de 5 kg
- Código del producto: DMT232
Control de calidad y estabilidad
El control de calidad se realiza en los laboratorios de MICROKIT.
Se recomienda repetir las pruebas en su propio laboratorio en los siguientes casos:
- Si el producto lleva más de 3 meses sin utilizarse.
- Tras desinfectar o reacondicionar el laboratorio.
- Si ha estado expuesto a altas temperaturas.
- Si presenta cambios de aspecto, incluso antes de la fecha de caducidad.
Aspecto esperado:
- Deshidratado: polvo marfil.
- Preparado: medio estéril de color marfil.
Ensayo de crecimiento (72 h a 28 °C aprox.)
| Microorganismo | Resultado | Descripción de colonias |
|---|---|---|
| Rhizobium leguminosarum USDA2370T | Excelente | Colonias mucosas, blancas-cremosas |
| Bradyrhizobium canariense BTA1T | Excelente | Colonias mucosas, blancas-cremosas |
| Ensifer meliloti ATCC 3390T | Excelente | Colonias mucosas, blancas-cremosas |
| Paenibacillus sp. GMPS02 | Excelente | Colonias mucosas, blancas-cremosas |
Modo de empleo e interpretación de resultados
Para el aislamiento de Rhizobium a partir de nódulos de leguminosas o tejidos endofíticos:
- Macerar los tejidos o nódulos en condiciones estériles.
- Sembrar por estría sobre la superficie del medio con una varilla o pellet pestle estéril.
- Incubar y observar el desarrollo de colonias blancas, cremosas y muy mucosas características de los Rhizobia.
Algunos endófitos no pertenecientes al género Rhizobium pueden mostrar un aspecto similar; se recomienda confirmación mediante pruebas adicionales.
Aplicaciones recomendadas
- Medio de aislamiento y cultivo rutinario de Rhizobia, bacterias endofíticas y rizobacterias que utilizan manitol como fuente de carbono.
- Medio base para otros endófitos o rizobacterias, añadiendo antes de la esterilización:
- 1 g/l de Extracto de Levadura Difco y/o
- 2 g/l de Triptona Difco.
Los géneros Bradyrhizobium, Mesorhizobium, Rhizobium y Sinorhizobium —todas las Rhizobiaceae que metabolizan manitol— crecen de forma excelente en el Rhizobium Agar USAL.
Responsabilidad y gestión de residuos
El usuario final es responsable de la destrucción de los microorganismos crecidos en el medio, conforme a la legislación medioambiental vigente.
Antes de desechar, autoclavar el material para garantizar su completa esterilización.
Distribución exclusiva
El Rhizobium Agar USAL es una patente de la Universidad de Salamanca (USAL), cuya fabricación y comercialización exclusivas corresponden a MICROKIT.
Contacto e información
Para conocer precios actualizados, disponibilidad o asesoramiento técnico, puede contactar con nosotros a través de:
microkit@microkit.es
91 897 46 16